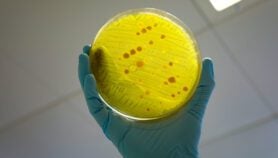
Drug resistance worsens UTI crisis in Malawi

Charles Pensulo
Profile
Charles Pensulo is a freelance journalist based in Malawi. He is interested in science, humanitarian, political, climate change and human rights stories. He has published with the Guardian, Thomson Reuters Foundation, and Al Jazeera among other international publications. Charles is also social media savvy and likes to engage with readers on different topics. He can be found on Charles Solomon Pensulo | Facebook and @charles_pensulo